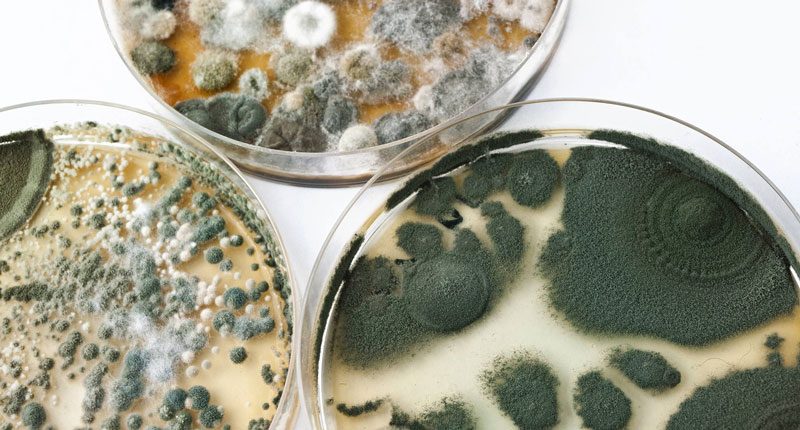

“Se si vuole contribuire al benessere del mondo, bisogna cominciare dalla propria casa”.
Non l’avrebbe, forse, mai detto, Mahatma Gandi. Ma questo suo aforisma, all’alba del terzo millennio segnato da una crisi economica non ancora superata e una crisi ecologica sempre più acuta, ha oggi una ancor più grande attualità e contemporaneità se considerassimo la quantità di anidride carbonica immessa in atmosfera a causa delle attività antropiche con il segmento dell’edilizia, insieme a quello delle infrastrutture, tra i più energivori e tra i principali corresponsabili dei cambiamenti climatici.
In questo scenario in continua evoluzione, nel quale, anche per le mutevoli istanze sociali, stanno subendo una profonda rivisitazione anche culturale tutti i fondamentali paradigmi tecnici, già da alcuni anni si sta affermando il modello della costruzione per prefabbricazione. Originariamente previsto e utilizzato per le architetture industriali, oggi questo sistema sta trovando un impiego crescente anche per le architetture residenziali. Con il legno, in modo particolare, a guidare questa “rivoluzione copernicana” e a sfatare, inoltre, molti luoghi comuni sulla sua performabilità. Se, infatti, le costruzioni prefabbricate, per definizione, hanno il vantaggio dell’economicità (si può risparmiare fino al 90% per i costi energetici), della rapidità e della qualità d’esecuzione con alcuni elementi fondamentali come pareti e solai realizzati negli stabilimenti industriali e poi soltanto assemblati in cantiere, a differenza delle ipotesi in cemento o in acciaio, la prefabbricazione in legno ha numerosissimi vantaggi.
Vediamoli in dettaglio: il legno è un materiale naturale, rinnovabile e riciclabile dopo il suo ciclo di vita, a differenza del cemento; il legno è capace di assicurare, pure con piccoli spessori, alte ed ottime proprietà di isolamento termo-acustico sia nel periodo invernale sia nel periodo estivo (per esempio con un isolante a fibra di legno ad alta densità o un “cappotto” ben installato che riduca al massimo i punti di discontinuità): con una buona progettazione che preveda sia la ventilazione trasversale sia l’esposizione a sud degli ambienti della cucina e del soggiorno con infissi altamente performanti, del resto, le proprietà di isolamento sarebbero esaltate; il legno, inoltre, disinnescando alcuni pregiudizi culturali anche per l’ausilio della tecnologia lamellare, oggi è resistente all’azione sismica e a quella degli incendi, reagendo meglio dell’acciaio e del cemento. A questo proposito, occorre ricordare che la velocità di carbonizzazione del legno è pari a solo 0,7mm al minuto e lo strato di carbone funge da protezione al fuoco per lo strato esterno, garantendo la portata dell’edificio per alcune ore, ossia per un tempo sufficiente per allontanarsi in sicurezza dalla costruzione; a differenza, invece, dell’acciaio che in presenza di alte temperature cede e fa collassare la struttura molto rapidamente.
Per il suo carattere elastico e per le sue proprietà meccaniche, poi, il legno – e il legno lamellare in particolare – reagisce meglio degli altri materiali all’azione sismica poiché l’energia indotta dal sisma è assorbita meglio dalla struttura lignea che presenta una maggiore deformabilità. La prefabbricazione, quindi, per quanto detto finora, assicura costruzioni sia ecologiche sia economiche, ma è opportuno, per una conoscenza più approfondita, individuare due diverse modalità di costruzione: il sistema con pareti a telaio e il sistema con pareti in Xlam.
Il sistema costruttivo a telaio, anche detto “platform frame”, è tra i più noti al mondo per la realizzazione di edifici e verte sulla formazione di una intelaiatura autoportante composta da pilastrini in legno lamellare che viene ancorata attraverso tirafondi in acciaio ad una fondazione in calcestruzzo armato originando una struttura “scatolare” indipendente piano per piano. Il vantaggio delle pareti a telaio è che l’isolante è posto all’interno tra i montanti e questo comporta una riduzione sensibile dello spessore della parete finita e un aumento della superficie utile calpestabile. Il sistema costruttivo in Xlam, invece, deve prevedere, prima di tutto, una buona progettazione poiché per la sua compatta e notevole rigidità diventerebbe difficile (ed oneroso) comportare modifiche in cantiere. Questa rigidità, tuttavia, soprattutto in caso di azione sismica, conferisce alla struttura una buona resistenza. Le pareti in Xlam, inoltre, presentano per l’isolamento termo-acustico il sistema del “cappotto” e, come le pareti a telaio, permettono di realizzare finiture esterne ed interne che risulteranno come una muratura.
Nonostante queste innovazioni, tuttavia, probabilmente per un fattore culturale, le costruzioni in muratura nel nostro Paese restano ancora largamente diffuse. Con molte aziende che stanno investendo in questo materiale per renderlo più competitivo e più versatile nei suoi usi per fornire agli operatori del settore un materiale capace di realizzare architetture flessibili e dinamiche. La prefabbricazione, infine, è possibile, come si diceva, anche con l’acciaio. Le costruzioni in acciaio, altamente tecnologiche, conferiscono una grande sicurezza in caso di azioni sismiche e, per le realizzazioni più eclettiche, possono descrivere il tratto creativo ed elegante del progettista, sebbene ha la criticità del suo comportamento in caso d’incendio. Concludendo, quindi, non si potrà dire, a priori, qual è la soluzione migliore dovendo essere analizzate tanto le esigenze personali del cliente, opportunamente suggerito da un progettista competente, quanto il contesto socio-ambientale, ma è indubbio che rispetto ai sistemi tradizionali in cemento-laterizio e in acciaio, la prefabbricazione in legno, come si è visto, oggi offra moltissimi vantaggi economici-ecologici.
Con questa soluzione che, ancor più oggi che da ciascuno sono richiesti comportamenti corresponsabili per salvaguardare la biosfera, rispetta l’invito gandhiano a proteggere e a valorizzare il mondo che viviamo.
Giuseppe Milano
L’aspetto che più colpisce nei progetti di Renzo Piano è sua la capacità di ricercare e dare, costantemente, risposte sempre nuove e sensibili alle tematiche di volta in volta affrontate. Il risultato sono opere sorprendentemente eterogenee, accomunate da una concezione di architettura integrata al contesto ed alla cultura locali ma, nello stesso tempo, proiettata verso il futuro dall’utilizzo (spesso commistionato) di materiali tradizionali e tecnologie d’avanguardia, in primis quelle rivolte alla sostenibilità. Quest’ultima costituisce una componente essenziale ed imprescindibile del progetto, con il quale nasce e si sviluppa in maniera “simbiotica”, e una delle ragioni per cui le architetture di Piano stupiscono ogni volta: inoltre le soluzioni sempre innovative che propone, derivano, solitamente, dall’applicazione di tali tecniche e tecnologie sostenibili costantemente all’avanguardia.
Ne è un esempio il progetto del nuovo quartiere Le Albere a Trento, elaborato e realizzato da Renzo Piano e dal suo studio e che ha visto la collaborazione anche di Albertani Corporates.
L’intervento interessa l’ex area industriale Michelin e, di fatto, ricostruisce un nuovo pezzo di città, estendendosi dall’antico Palazzo delle Albere fino alla sponda dell’Adige. Ha come obiettivo il recupero e la ricucitura del rapporto della zona sia con il tessuto urbano esistente (quello consolidato della città storica) sia con il contesto fluviale. Inoltre l’insediamento qui di un mix funzionale (abitazioni, uffici, spazi culturali commerciali e ricreativi, centro polifunzionale) intende restituire nuovo slancio e vitalità ad un’area che negli anni è stata via via emarginata.
L’impostazione del progetto è incentrata sulla definizione di un asse Nord-Sud, rettilineo e pedonale, che congiunge i due poli, individuati, rispettivamente, dal M.U.S.E. – Museo delle Scienze, e dal centro polifunzionale. Un secondo asse, curvo e segnato dall’acqua, sottolinea ulteriormente il collegamento tra i due edifici e, nello stesso tempo, funge da elemento di transizione tra l’area costruita e quella naturale, rappresentata dall’ampio parco (circa 5 ettari). Questo nuovo polmone verde della città e parte integrante del progetto, interessa tutta la zona Ovest e va a fondersi con il contesto naturale dell’argine dell’Adige. La presenza dell’acqua costituisce uno degli elementi caratterizzanti dell’intervento: infatti un sistema di canali attraversa tutta l’area in direzione Nord-Sud, alimentando due specchi d’acqua che circondano gli edifici pubblici e costituendo, nello stesso tempo, una riserva idrica utilizzabile a fini di irrigazione ed antincendio.
Gli altri edifici, 18 palazzine per un totale di circa 350 unità abitative, si concentrano ad Est: presentano tipologia prevalentemente in linea o a corte, con tagli orizzontali che consentono alla vista di spaziare dalla strada ai giardini condominiali, ed altezze massime che non superano i quattro o cinque piani per mantenere il rapporto con la scala della città storica. Ciascuna unità dispone inoltre di una quota di verde privato, consistente in un piccolo giardino o in un loggiato. Al di sotto delle abitazioni è stato realizzato un grande parcheggio sotterraneo per circa 2000 posti auto.
Dal punto di vista architettonico gli edifici sono stati realizzati prevalentemente in legno, con l’impiego di spessori importanti di isolamento termico allo scopo di garantire l’efficienza energetica passiva dell’involucro. Le facciate sono state ottenute attraverso l’utilizzo di moduli di legno da 3,75 m, in cui si inseriscono i sistemi di logge e finestre che si adattano a seconda delle diverse funzioni interne.
L’uso di questo materiale, oltre a costituire la cifra stilistica dell’intervento, risponde anche ad esigenze “etiche”. Lo stesso Renzo Piano lo descrive nel modo seguente: “Tutto il progetto è concepito e realizzato per risparmiare energia ed essere ragionevoli e sostenibili sul piano della gestione, perché l’ispirazione di base su cui si apre questo nuovo secolo per un architetto è capire che la fragilità della Terra non va soltanto difesa facendo economia, ma anche andando a cercare quali sono le espressioni architettoniche migliori. Usare il legno è già di per sé un’attività intelligente, non solo perché siamo a Trento, ma perché è un materiale nobile, antico, è un materiale che viene dalle foreste, e le foreste si rinnovano, per cui di fatto è energia rinnovabile oltre che perfettamente riciclabile”.
Marciapiedi e percorsi sono invece identificati dall’uso di pietra tradizionale, nelle due varianti di verdello e rosso Trento, presente anche nel centro storico: essa riveste inoltre i muri dei piani terra, i corpi scala e le facciate opache degli edifici pubblici, stabilendo, in questo modo, un sistema gerarchico di spazi e funzioni.
Le coperture in zinco assicurano continuità visiva al complesso e prevedono particolari accorgimenti studiati allo scopo di limitare la visibilità di prese d’aria e camini: su di esse sono stati installati pannelli fotovoltaici che, insieme ad otto sonde geotermiche, assicurano il funzionamento delle pompe di calore per il riscaldamento invernale ed il raffrescamento estivo.
Tutti gli edifici residenziali hanno ricevuto il riconoscimento Casa Clima livello B, mentre il progetto è risultato uno dei vincitori dei Casa Clima Awards 2013; al MUSE è stato inoltre attribuita la certificazione LEED Gold.
Quest’ultimo edificio segnala e caratterizza con la sua presenza il polo Nord dell’area, richiamando grazie ad un profilo fortemente riconoscibile, le vette delle montagne circostanti. Costituisce, insieme al resto dell’intervento, un eccellente esempio di progettazione attenta alla sostenibilità ed all’efficienza energetica. Come le altre strutture, anch’esso è stato realizzato in materiali scelti in base a criteri di rinnovabilità e reperibilità locale, cioè legno (strutture), pietra verdello e bambù (pavimentazione delle aree espositive).
Dal punto di vista energetico è quasi esasperato il ricorso alle energie rinnovabili: celle fotovoltaiche, pannelli solari e sonde a scambio termico consentono di sfruttare l’energia solare e geotermica, mentre serbatoi per il recupero dell’acqua piovana, pannelli radianti a pavimento e lucernai domotizzati garantiscono risparmio d’acqua, riscaldamento ottimale, ventilazione e illuminazione naturali.
Elena Ottavi
Quando si parla di inquinamento dell’aria, spesso lo si tende ad associare soltanto alle sostanze nocive che produciamo ed emettiamo nell’atmosfera, o allo smog che opprime le nostre città. In realtà esiste una forma di inquinamento, poco conosciuta e a volte sottovalutata, i cui rischi possono essere ben più gravi: si tratta dell’inquinamento indoor, che riguarda gli ambienti confinati in cui svolgiamo attività di diverso tipo. Abitazioni, scuole, uffici, edifici pubblici, mezzi di trasporto (sono esclusi gli ambienti industriali) sono luoghi in cui trascorriamo gran parte delle nostre giornate (circa l’80-90% secondo le stime) ed in cui, come hanno dimostrato diverse ricerche e pubblicazioni, l’esposizione ad inquinanti di varia natura può essere addirittura superiore rispetto a quella presente all’esterno. Un’ulteriore aggravante è rappresentata dal fatto che le categorie più colpite sono quelle più deboli, come i bambini, gli anziani e i soggetti che presentano patologie che li rendono più suscettibili agli effetti nocivi di alcune sostanze.
I dati raccolti dall’O.M.S. classificano l’inquinamento indoor addirittura come la principale causa di decesso legata all’ambiente e stimano che nel 2010 esso abbia determinato un numero di morti compreso fra 3,5 e 4 milioni. Inoltre circa la metà dei decessi di bambini di età inferiore ai 5 anni sarebbe riconducibile ad infezioni respiratorie acute collegate all’inalazione di aria domestica inquinata (dati OMS 2014).
Le principali patologie a cui l’esposizione ad inquinamento indoor può portare, sono quelle riguardanti gli apparati cardio-circolatorio e respiratorio, a partire da disturbi leggeri come tosse, irritazioni e forme allergiche per arrivare a problemi più gravi, come bronchiti, polmoniti, asma, cardiopatie, cancro. Da qualche anno si è iniziato a parlare anche di Sick Building Syndrome (S.B.S.), tradotto in italiano come sindrome da edificio malato, con cui si indicano i sintomi, manifestati da una o più persone, riconducibili al tempo trascorso all’interno di un edificio ma non identificabili come malattie specifiche.
Ma quali sono le sostanze nocive che sono alla base di questi problemi? E come possiamo difenderci?
Sono diverse e di varia natura: polveri, batteri, spore, muffe, composti organici volatili, gas, ecc. Alcune derivano da nostri comportamenti o cattive abitudini e spesso i loro effetti sono aggravati dalle esigenze di isolamento termo-acustico degli edifici: la mancante o insufficiente ventilazione degli ambienti interni costituisce infatti ostacolo alla possibilità di dispersione all’esterno degli eventuali agenti pericolosi.
Tra le fonti più comuni di inquinamento indoor troviamo il fumo di tabacco, i processi di combustione, la presenza di animali domestici, l’uso di molti prodotti per la pulizia e la manutenzione della casa, gli antiparassitari, l’impiego di colle, adesivi e solventi, l’utilizzo di strumenti come stampanti e fotocopiatrici.
Un capitolo importante è quello relativo alle emissioni prodotte dai materiali impiegati nella costruzione degli edifici. Da questo punto di vista, il più (tristemente) famoso è il rischio amianto, ampiamente sfruttato in ambito edilizio negli anni Sessanta e Settanta per le sue notevoli prestazioni come isolante termo – acustico e per la resistenza al fuoco. Per questo capita spesso anche oggi, nel corso di interventi di ristrutturazione, di imbattersi in questo materiale (coperture, serbatoi, canne fumarie, ecc.), la cui pericolosità consiste nello sfaldamento delle fibre che si disperdono, penetrano nel sistema respiratorio e provocano gravi patologie. Oggi, nonostante siano stati vietati l’uso, l’estrazione e la trasformazione dell’amianto, non siamo comunque del tutto lontani dai fattori di rischio. Da un lato occorre prestare attenzione al pericolo legato all’utilizzo di malte che impiegano cemento (falsamente sostenibile) proveniente da materiali di riciclo: potrebbero infatti contenere residui di amianto o altri metalli pesanti. Dall’altro il mercato dei materiali da costruzione abbonda di composti sintetici, come polistirolo e polistirene, impiegati nell’isolamento degli edifici, i quali, oltre ad ostacolare la necessaria traspirazione delle pareti, emettono nell’ambiente interno sostanze volatili pericolose e residui di elementi chimici assorbiti durante i processi di trasformazione. In questi casi un accorgimento non risolutivo ma comunque utile, è quello di assicurare la ventilazione durante e dopo la posa in opera di questi materiali.
Tra i fattori di rischio più diffusi legati ai materiali da costruzione più direttamente a contatto con chi abita o vive l’ambiente indoor vi sono anche quelli derivanti dall’utilizzo di colle e vernici ed elementi in PVC. Anche questi materiali sono di origine chimico-sintetica e, nel corso del loro ciclo di vita, emettono nell’aria sostante nocive per la salute dell’uomo denominate composti organici volatili (C.O.V.), tra cui ci sono, ad esempio, benzene e formaldeide La presenza di quest’ultima, in particolare, all’interno delle abitazioni, è dovuta ad una moltitudine di cause: la si trova in vernici e pitture, negli oggetti d’arredamento, in colle e resine, nei rivestimenti, nei processi di combustione. Anche in questo caso si consiglia di ventilare abbondantemente i locali dopo che vi sono stati introdotti prodotti (ad esempio mobili) a rischio e, comunque, di cercare di preferire, al momento dell’acquisto, quelli naturali o che garantiscono e certificano un basso contenuto di composti organici volatili.
La qualità dei materiali impiegati nella costruzione delle abitazioni consente di prevenire anche l’insorgere di problemi come condense, muffe e formazioni di umidità ed il conseguente proliferare di funghi e batteri: infatti se da un lato vi sono materiali plastici o di origine sintetica, non traspiranti, che favoriscono la comparsa di questi fenomeni, dall’altro vi sono anche quelli capaci di contribuire al comfort abitativo e di filtrare e depurare l’aria interna dell’abitazione. Fra questi troviamo il legno, che, per sua natura risulta anallergico, traspirante ed in grado di schermare anche altri fenomeni nocivi quali i campi elettromagnetici.
Infine vi sono i rischi legati agli aspetti impiantistici delle abitazioni, in particolare ai sistemi di ventilazione, climatizzazione e deumidificazione: la loro eventuale cattiva manutenzione o errata collocazione (ad esempio se ci sono prese d’aria su strade molto trafficate) può favorire l’ingresso in casa di sostanze e polveri nocive dall’esterno ed il proliferare, all’interno di filtri non adeguatamente puliti, di acari, muffe, batteri ed altri contaminanti biologici che potrebbero causare asma e reazioni allergiche.
Questi sono solo alcuni dei fattori in gioco nell’ambito del rischio espositivo all’inquinamento indoor, del quale risulta tuttavia difficoltoso costruire una stima quantitativa univoca e definire un quadro omogeneo. Oltre alla presenza o meno degli agenti inquinanti, risultano infatti determinanti anche altri elementi legati ai singoli contesti, alla tipologia di individui (età, suscettibilità alle malattie, presenza di altre patologie croniche, ecc.), ai tempi di esposizione. Come buona prassi, rimane comunque consigliabile accertarsi bene, in fase di progettazione ed acquisto, della qualità e della tipologia dei materiali da impiegare all’interno delle abitazioni e, durante e dopo la loro posa in opera, garantire la ventilazione e il ricambio d’aria negli ambienti indoor.
Elena Ottavi
Negli ultimi anni l’aumento della sensibilità e dell’interesse per le tematiche relative alla tutela dell’ambiente e delle sue risorse, ha contribuito alla notevole crescita, sia quantitativa sia qualitativa, dei settori che ruotano intorno all’architettura sostenibile. Di conseguenza è notevolmente aumentata l’attenzione che viene riservata al legno, considerato e riconosciuto come “il materiale sostenibile per eccellenza”.
Le caratteristiche che lo contraddistinguono garantiscono numerosi ed innegabili vantaggi. Innanzitutto è dotato di proprietà fisiche e meccaniche, che gli conferiscono estrema versatilità e, nei vari casi, capacità di adeguamento alle diverse esigenze: leggerezza, resistenza, elasticità ed indeformabilità lo rendono in grado di garantire ottime prestazione anche dal punto di vista delle sollecitazioni sismiche o quando viene impiegato in progetti complessi, come la realizzazione di grandi strutture di ingegneria.
Inoltre, a dispetto di quanto saremmo comunemente portati a pensare, il legno vanta anche un eccellente comportamento al fuoco: infatti, dati la sua resistenza ed il grado di umidità interna, risulta un materiale cattivo conduttore di calore e, aspetto fondamentale, dal comportamento prevedibile. Questo non significa che il legno non bruci, ma che i processi di combustione che lo intaccano, producono la formazione di un sottile strato esterno carbonizzato, in grado di isolare termicamente la sezione (adeguatamente dimensionata) interna dell’elemento, salvaguardandone le proprietà meccaniche e quindi la capacità di continuare a svolgere il proprio compito senza rischi di cedimenti improvvisi.
Ci sono poi gli aspetti legati all’isolamento: il legno è, per sua natura, un materiale cellulare, poroso e traspirante e quindi ottimo nell’assorbimento del rumore e delle vibrazioni e nel garantire equilibrio termo-igrometrico ed isolamento termico degli ambienti.
In ultimo, ma non per importanza, troviamo le caratteristiche relative al risparmio energetico, all’efficienza, alla riduzione dei consumi, in una parola, alla sostenibilità: il legno è infatti un materiale vivo e rinnovabile e, in quanto tale, consente, più di altri ed in maniera naturale, la riduzione dell’impatto ambientale e dello spreco di risorse. In fase produttiva contribuisce anche al miglioramento della qualità dell’aria grazie alla fotosintesi clorofilliana, attraverso cui si depura l’atmosfera dell’anidride carbonica e le si restituisce ossigeno.
Tuttavia l’utilizzo sempre più esteso del legno e dei suoi derivati come materia prima per le opere di costruzione viene spesso erroneamente associato alla diffusione del problema della deforestazione: si può infatti essere portati a pensare che la necessità di incrementare la produzione di questo materiale possa produrre il conseguente aumento del numero di alberi abbattuti a tale scopo. Ma non è così: infatti il legno destinato ad essere impiegato in ambito costruttivo proviene da risorse boschive controllate e gestite in maniera sostenibile, in cui le piante più vecchie vengono espiantate e sostituite da uno o più esemplari più giovani e più efficienti dal punto di vista della fotosintesi clorofilliana. Come per gli esseri umani, infatti, anche gli alberi invecchiando vedono rallentare il proprio “metabolismo” e le funzioni vitali e ridursi, di conseguenza, la quantità di ossigeno prodotto. Sostituendo tali esemplari con altri più giovani, si mantiene perciò al massimo il livello di fotosintesi.
Inoltre, a tutela delle risorse boschive mondiali, da alcuni anni sono in attività anche enti internazionali impegnati nella certificazione della gestione sostenibile delle foreste e delle attività legate alla filiera del legno (legno, cellulosa, carta). Tali enti si occupano di verificare, in maniera indipendente e terza, che il legname impiegato sia prodotto nel rispetto di condizioni di sostenibilità (ambientale, sociale ed economica), e che ne sia garantita la tracciabilità per tutto il processo di trasformazione fino al consumatore finale.
A livello internazionale ci sono due grandi schemi di certificazione: il Programme for the Endorsement of Forest Certification – PEFC (www.pefc.org) e il Forest Stewardship Council – FSC (www.fsc.org), al cui interno opera anche Greenpeace. Si tratta di due schemi sostanzialmente equivalenti, come affermato anche dal Parlamento Europeo con la risoluzione INI/2005/2054 del 16/02/2006 con cui definisce PEFC e FSC “ugualmente in grado di fornire garanzia al consumatore che i prodotti certificati a base di legno e carta derivino da gestioni forestali sostenibili”.
Entrambi gli schemi richiedono il rispetto dei principi di legalità e di sostenibilità ambientale e sociale e delle convenzioni sulla tutela della salute e dei diritti dei lavoratori delle popolazioni indigene coinvolte in tutta la filiera.
FSC è una organizzazione non governativa, indipendente e senza scopo di lucro, che opera per migliorare la gestione delle foreste in tutto il mondo, in un’ottica, appunto, di sostenibilità. Riunisce vari tipologie di figure (ambientalisti, comunità che vivono nelle foreste, proprietari di foreste, industrie di lavorazione e commercializzazione del legno, tecnici, ecc.) che, tutte insieme, hanno sviluppato uno schema atto a garantire lo sfruttamento sostenibile delle risorse boschive attraverso l’identificazione dei “prodotti contenenti legno proveniente da foreste gestite in maniera corretta e responsabile secondo rigorosi standard ambientali, sociali ed economici” (Fonte: www.it.fsc.org).
PEFC, invece, è un’associazione indipendente, non-profit e non governativa, che ha come obiettivo la “definizione dei criteri e degli indicatori della ‘gestione forestale sostenibile'(GFS), ovvero di parametri quantitativi e qualitativi (descrittivi) che, quando periodicamente misurati o osservati, permettano di valutare le performance ambientali e la sostenibilità dei sistemi di gestione forestale” (Fonte: www.pefc.it). Le aziende che gestiscono lo sfruttamento delle risorse boschive sono controllate, secondo gli standard PEFC, allo scopo di escludere che il legname sia tagliato illegalmente, che venga minacciata la conservazione della foresta, che vengano introdotti organismi dannosi o geneticamente modificati nella coltivazione o che siano violati i diritti civili dei lavoratori e degli indigeni (laddove presenti).
Il riconoscimento internazionale di tali certificazioni consente quindi di promuovere l’immagine del legno come materia prima rinnovabile e di favorire lo sviluppo di sistemi virtuosi di produzione di questa materia prima, basati su criteri di gestione responsabile e sostenibile delle risorse boschive mondiali e che prendono nettamente posizione contro le azioni incontrollate di disboscamento, l’uso di prodotti chimici tossici o l’introduzione di organismi e specie dannosi.
Arch. Elena Ottavi
Versatile e duttile. Resistente e performante. Elegante ed intrigante. Il legno, nonostante sia da decenni periodicamente messo in discussione soprattutto per le sue caratteristiche strutturali che non lo renderebbero competitivo rispetto al calcestruzzo e all’acciaio, riesce sempre, alla fine, ad imporre il suo credo. E il suo fascino. Riuscendoci oggi, ancor più, in uno scenario internazionale nel quale è fondamentale coniugare insieme le ragioni della qualità con quelle della sostenibilità; nel quale occorre saldare le dimensioni economiche ed ecologiche; nel quale, inoltre, bisogna saper frequentare la modernità unendo la memoria della tradizione con l’utopia dell’innovazione. Per questo, durante il Salone del Mobile di Milano del 2010, l’architetto Matteo Thun ha dichiarato che “il legno è il materiale del XXI secolo ed essendo l’unico materiale da costruzione rigenerabile non è più possibile immaginare il design e l’architettura senza di esso”. Usare il legno in edilizia, peraltro, significa mettere in moto una filiera virtuosa che va decisamente incontro alle richieste delle politiche europee di salvaguardia del pianeta e di controllo dei cambiamenti climatici. Il legno, del resto, è l’unico materiale edile rinnovabile e riciclabile; ha una buona resistenza meccanica; una bassa conducibilità termica; una buona capacità adsorbente e riflettente delle vibrazioni acustiche; non è tossico e neutralizza le emissioni di CO2. Non solo, quindi, edifici residenziali monofamiliari, ma oggi il legno – supportato e corroborato nei suoi molteplici usi dalle più evolute tecnologie industriali – può essere impiegato per edifici “torre”, per auditorium e padiglioni, per musei e mercati. Nel segno della leggerezza, ma anche dell’eleganza architettonica, vediamo alcuni esempi, tra i tanti distribuiti in Europa e nel mondo.
Svezia. Ad oggi è solo un progetto fortemente d’avanguardia, ma il grattacielo “Wooden Skyscraper” – atteso per il 2023 – potrebbe far diventare la città di Stoccolma, e il suo quartiere Marieberg, la sede della torre in legno più alta del mondo, con i suoi 34 piani. Realizzata interamente in legno, con alcune parti della struttura in cemento armato. Le ampie vetrate isolanti, i giardini pensili, i pannelli solari sul tetto e il sistema di raccolta delle acque piovane faranno del grattacielo di legno di Stoccolma un evoluto esempio di bioarchitettura ad alta efficienza energetica e a bassi consumi. Nella volontà di diffondere ulteriormente la consapevolezza che il legno non è solo un materiale da costruzione solido e flessibile, ma anche resistente e versatile. Un materiale, assolutamente rinnovabile ed eco-compatibile, che oggi, opportunamente trattato, resiste più a lungo agli incendi e all’umidità.
Finlandia. Pur essendo da tempo un materiale ampiamente utilizzato, il complesso residenziale Puukuokka è il primo esempio di edificio da 8 piani realizzato in Finlandia. Primo volume di una triade di architetture sostenibili, alla fine dell’intervento si prevedono 150 nuove unità residenziali su un’area complessiva di 10.000 mq. I blocchi sono stati realizzati con moduli cubici prefabbricati in legno CLT, avvalendosi del sistema Urban MultiStory sviluppato da Stora Enso. La scelta di adottare soluzioni prefabbricate ha offerto al contempo abitazioni a costi contenuti, ecosostenibili e adattabili ai mutamenti delle esigenze abitative nel tempo. Anche per la facciata è stato utilizzato il medesimo principio. Il corridoio centrale è l’unica parte del complesso realizzata in loco, una scelta che ha accorciato le tempistiche a soli sei mesi, un aspetto fortemente positivo dato il contesto climatico della Finlandia. Tutto questo ha reso possibile il raggiungimento di un livello qualitativo nel risultato finale superiore a quanto ottenibile con i metodi tradizionali.
Azerbaigian. Il padiglione del Paese caucasico all’Expo di Milano, progettato dallo studio Simmetrico, propone una rappresentazione dell’architettura come energia positiva e propositiva, tesa all’armonizzazione e alla protezione delle differenze. Gli elementi architettonici iconici, le biosfere e le pareti ondulate, sono state concepite per rappresentare metafore naturali e culturali. Le biosfere sono metafora del sistema-paese nel quale elementi differenti convivono in perfetto equilibrio, originando crescita e sviluppo. Il louver, una “pelle” in legno, che si sviluppa sui lati più lunghi del padiglione come un involucro protettivo, racconta la metafora del vento, elemento caratteristico del Paese che abbraccia e protegge l’Azerbaigian, rappresentando i flussi culturali che da sempre lo attraversano. Oltre alla varietà spaziale, infine, la luce e la trasparenza sono tra le principali scelte su cui poggia l’architettura del padiglione. Scelte che garantiscono l’eccezionalità richiesta per la rappresentazione dell’evento, pur mantenendo forme utili anche a sostenere il bilancio energetico dell’edificio.
Spagna. Il Metropol Parsol nasce, a Siviglia, con l’obiettivo di riqualificare e rifunzionalizzare l’antica Plaza de la Encarnacion. La piazza, che sorge sull’incrocio tra il cardo e il decumano della città romana, è stata per secoli la sede del più grande mercato cittadino prima di venire abbandonata nel 1973 dopo la demolizione dello stesso mercato. La struttura, progettata dall’architetto tedesco Jürgen Mayer, si sviluppa su cinque livelli, di cui uno seminterrato, e accoglie diverse funzioni cittadine. La struttura, oggi nuova icona della città andalusa, è totalmente incorniciata da una serie di “ombrelloni” in legno che le conferiscono un aspetto completamente astratto. La mega struttura di reticoli in legno – lunga circa 150m, profonda 75m e alta 28m – è disposta su un griglia ortogonale di 1,50m x 1,50m e poggia su soli sei supporti. Per contenere le spese di realizzazione, sulla base delle evidenze progettuali elaborate dallo studio Arup, è stato deciso di sviluppare la struttura in un legno micro-laminato (Kerto), protetto dagli agenti esterni grazie a un rivestimento in poliuretano resistente all’acqua.
Giuseppe Milano
“La città è una stupenda emozione dell’uomo. La città è un’invenzione, anzi: è l’invenzione dell’uomo”.
Far riecheggiare questa riflessione dell’architetto Renzo Piano nel “paesaggio” della nostra immaginazione può servire per orientarci nell’esplorazione del tema della rigenerazione urbana.
La necessità di contenere l’espansione del tessuto antropizzato e quella di riqualificare il patrimonio costruito derivano, infatti, da un combinato disposto di motivazioni politiche-economiche da un lato e sociali-ambientali-culturali dall’altra. Le città, che secondo le stime dell’Onu potrebbero ospitare fino a 9 miliardi di persone entro il 2050 (ossia, oltre l’80% della popolazione globale), nell’ultimo decennio sono state travolte da due fenomeni globali: la crisi economica-finanziaria e i cambiamenti climatici. Due processi che, per il loro carattere sistemico, stanno obbligando gli organi politici istituzionali ad agire per una rivisitazione strutturale dei paradigmi finora vigenti.
L’attuale modello economico lineare improntato al consumo illimitato di risorse limitate, attraverso i combustibili fossili, ha determinato ecosistemi urbani sempre più fragili ed instabili, oltre che invivibili. Si pensi al suolo: erroneamente ritenuta risorsa rinnovabile, si è scoperto, invece, che non solo non lo è – occorrendoci quasi 500 anni per riprodurre 2,5 cm di terreno – ma anche che dalla sua indispensabile protezione e valorizzazione ecologica dipende il nostro futuro. Sebbene oggi la tendenza sia opposta.
“L’impermeabilizzazione del suolo (soil sealing) – scrive Paolo Pileri, docente di Pianificazione Territoriale al Politecnico di Milano – rappresenta la principale causa di degrado del suolo in Europa, in quanto comporta un rischio accresciuto di inondazioni, contribuisce al riscaldamento globale, minaccia la biodiversità, suscita particolare preoccupazione allorché vengono a essere ricoperti terreni agricoli fertili, aree naturali e seminaturali, e contribuisce – insieme allo sprawl urbano – alla progressiva e sistematica distruzione del paesaggio, soprattutto rurale”.
Come rivela da alcuni anni l’Ispra, per il consumo di suolo nel nostro Paese, che procede alla velocità di oltre 7 mq al secondo, ogni giorno perdiamo quasi 55 ettari di suolo agricolo. Si stima che il 7% della superficie italiana – pari a 21mila Kmq – sia impermeabilizzato, a causa della costruzione di edifici e infrastrutture. Una percentuale pari a quasi il doppio della media europea. E, se negli anni Cinquanta, questa espansione era comprensibile per un Paese da ricostruire dopo la stagione bellica, oggi, a fronte di un vistoso calo demografico e di un altrettanto chiaro processo di emigrazione delle più giovani generazioni, non lo è più. Tra i pochi Paesi europei che non si sono ancora dotati di una legge per limitare il consumo di suolo agricolo, l’Italia ha oltre 4 milioni di alloggi vuoti e migliaia sono i siti militari, ospedalieri e industriali dismessi, degradati o da bonificare.
A questo mosaico, tuttavia, occorre aggiungere un’altra tessera. L’eccessiva urbanizzazione, spesso realizzata abusivamente o in contesti geografici già precari come le lame o i letti dei fiumi, ha corroborato gli impatti del dissesto idrogeologico e sta imponendo l’elaborazione di innovativi piani “resilienti” per mitigare gli effetti dei cambiamenti climatici. E il principale provvedimento per “salvare” le città e chi le vive è, appunto, prevedere interventi strutturali di rigenerazione urbana.
Agendo sul patrimonio costruito e secondo un approccio integrato capace di decodificare la complessità odierna delle città, infatti, si otterrebbero una molteplicità di vantaggi: limitare la nascita di nuove periferie e il consumo di nuovo suolo agricolo; riqualificare, staticamente e funzionalmente, un patrimonio architettonico-storico anche di pregio molto spesso ubicato nelle zone più strategiche delle nostre urbanità; restituire, nei casi di demolizione e ricostruzione – secondo i dettami della bioarchitettura – di quegli organismi edilizi particolarmente vetusti e obsolescenti, una centralità agli spazi pubblici posti in dialogo con i nuovi edifici; valorizzare le energie rinnovabili e le soluzioni tecnologiche improntate all’efficienza energetica anche a scala di quartiere e non più rispetto al singolo volume; rinsaldare la coesione sociale attraverso i processi partecipativi dei cittadini “proattivi” che hanno la voglia di cooperare e condividere soluzioni sul riuso degli immobili degradati; creare potenzialmente nuova occupazione per giovani o disoccupati che costituiscono consorzi o cooperative per gestire questi patrimoni fornendo, contestualmente, un grande aiuto alle Amministrazioni Comunali in difficoltà per le varie restrizioni burocratiche-economiche vigenti.
La rigenerazione urbana, quindi, se affrontata con uno sguardo visionario proiettato al futuro e se declinata nel quotidiano mediante un approccio sistemico e multidisciplinare, favorisce l’inclusione sociale e promuove nuovi modelli di coesione territoriale da un lato; e incentiva, per dirla con le parole di Alex Langer, quella “conversione ecologica”, anche socio-culturale, delle nostre comunità, dall’altro.
In pochi anni, in tutto il Paese, migliaia sono stati gli interventi integrati di rigenerazione urbana connotati da una forte impronta ecologica che hanno avuto anche notevoli impatti sociali. Interventi che, sempre più spesso, vedendo il coinvolgimento diretto dei cittadini, stanno riscrivendo la storia dell’urbanistica contemporanea e rimodulando l’evoluzione della pianificazione territoriale. Operazioni, infine, che hanno restituito e che consegneranno, almeno nelle intenzioni più nobili, un’estetica e una piacevolezza visiva via via crescente alle nostre città nei prossimi anni.
Con l’auspicio che presto, nel mondo, l’Italia torni ad essere “il Bel Paese” per la riscoperta bellezza delle sue città.
Giuseppe Milano

Albertani Corporates SpA
Sede legale e amministrativa
Via Corsica 143
25125 Brescia, Italia
Tel +39 0364 773511
info@albertani.com
Ultime dal blog
 Coworking, cohousing e coliving. Quando sostenibilità fa rima con condivisione7 Dicembre 2018 - 12:20
Coworking, cohousing e coliving. Quando sostenibilità fa rima con condivisione7 Dicembre 2018 - 12:20 Cambiamenti climatici: le case galleggianti sono un’ancora di salvezza?16 Novembre 2018 - 15:32
Cambiamenti climatici: le case galleggianti sono un’ancora di salvezza?16 Novembre 2018 - 15:32